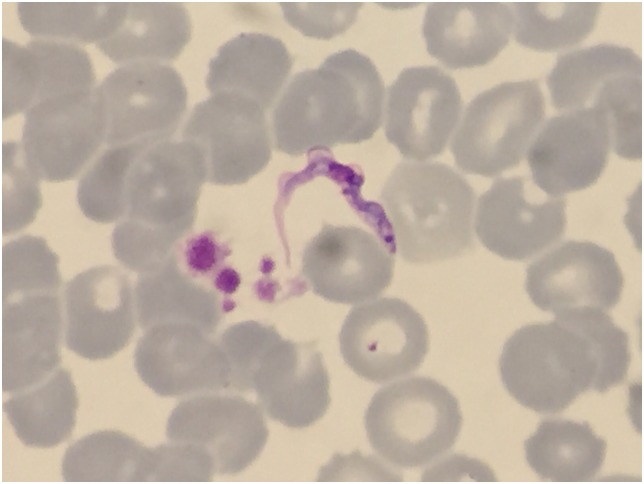
term image
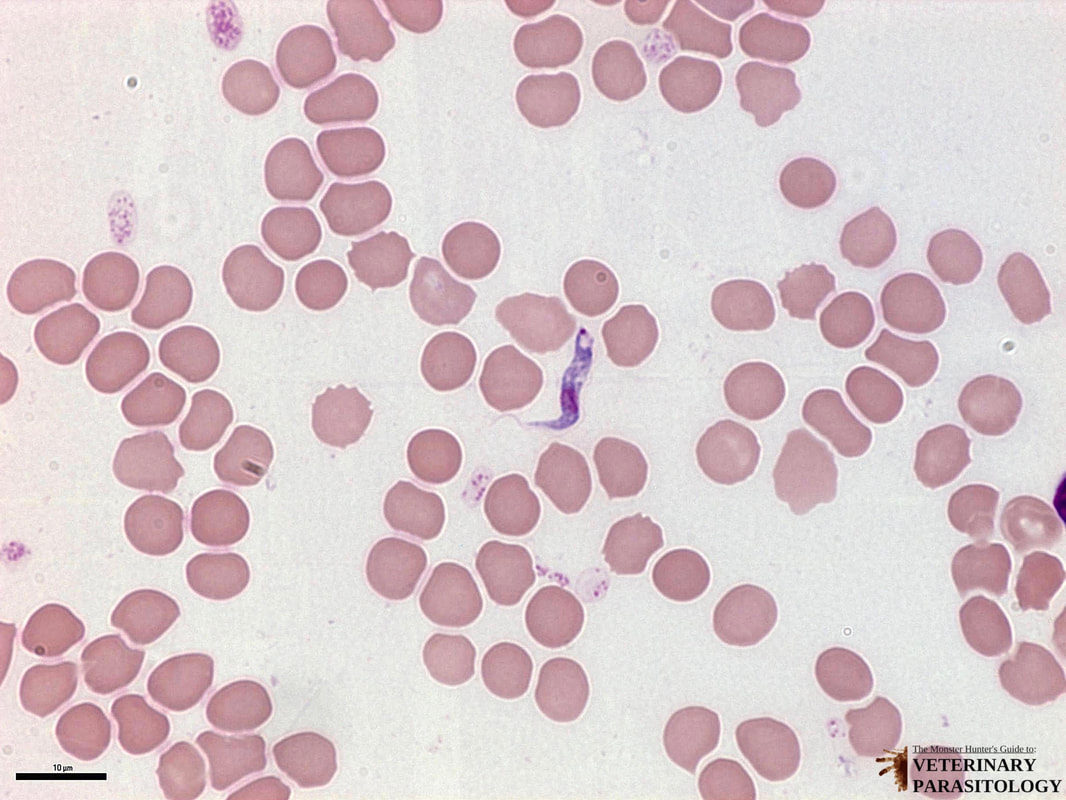
term image
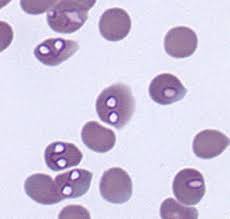
term image

pierwotniaki zdjęcia mikroskopowe
0.0(0)
Studied by 0 peopleCard Sorting
1/38
Earn XP
Last updated 5:10 PM on 3/9/23
Name | Mastery | Learn | Test | Matching | Spaced | Call with Kai |
|---|
No analytics yet
Send a link to your students to track their progress
39 Terms
1
New cards

trypanosoma brucei, trypomastigota
2
New cards
trypanosoma brucei, typomastigota
3
New cards
trypanosoma brucei. trypomastigota
4
New cards

trypanosoma cruzi epimastigota
5
New cards

trypanosoma brucei epimastigota
6
New cards

trypanosomacruzitrypomastigota
7
New cards

trypanosoma cruzi trypomastigota
8
New cards

trypanosoma cruzi amastigota
9
New cards

trypanosoma cruz amastigota
10
New cards

leishmania donovani promastigota
11
New cards

leishmania donovani promastigota
12
New cards

leishmania donovani amastigota
13
New cards

giardia intestinalis trofozoit
14
New cards

giardia intestinalis cysta
15
New cards

giardia intestinalis cysta
16
New cards

trichomonas vaginalis __**trofozoit**__
17
New cards

entamobea histolityca trofozoit
18
New cards

entamobea histolityca trofozoit (dobrze widoczne jądro “kwiatkowe”)
19
New cards

entamobea histolityca cysta
20
New cards

entamobea histolityca cysta
21
New cards

cryptosporidium spp. oocysta ze sporozoitami
22
New cards

cryptosporidium spp. oocysta ze sporozoitami
23
New cards

toxoplasma gondii tachyzoit
24
New cards

toxoplasma gondii tachyzoit
25
New cards

toxoplasma gondii bradyzoit w cyście tkankowej
26
New cards

toxoplasma gondii bradyzoit w cyście tkankowej
27
New cards

toxoplasma gondii cysta nieinwazyjna → inwazyjna
28
New cards

eimeria spp (niewysporulowana, wysporulowana z 2 sporozoitami)
29
New cards
podaj wszystkie gatunki plasmodium
falciparum, knowlesi, malariae, ovale, vivax
30
New cards

\
sporozoit plasmodium vivax sporozoit
31
New cards

plasmodium vivax trofozoit
32
New cards

plasmodium falciparum schizont (trofozoit)- faza egzoerytrocytarna
33
New cards

plasmodium falciparum faza pierścienia (młody trofozoit) - faza endoerytrocytarna
34
New cards
babeshia canis merozoit
35
New cards

babeshia microti merozoit (krzyż maltański)
36
New cards

balantioides coli trofozoit
37
New cards

balantioides coli cysta
38
New cards

balantioides coli trofozoit
39
New cards

\
trichodina mutabilis trofozoit